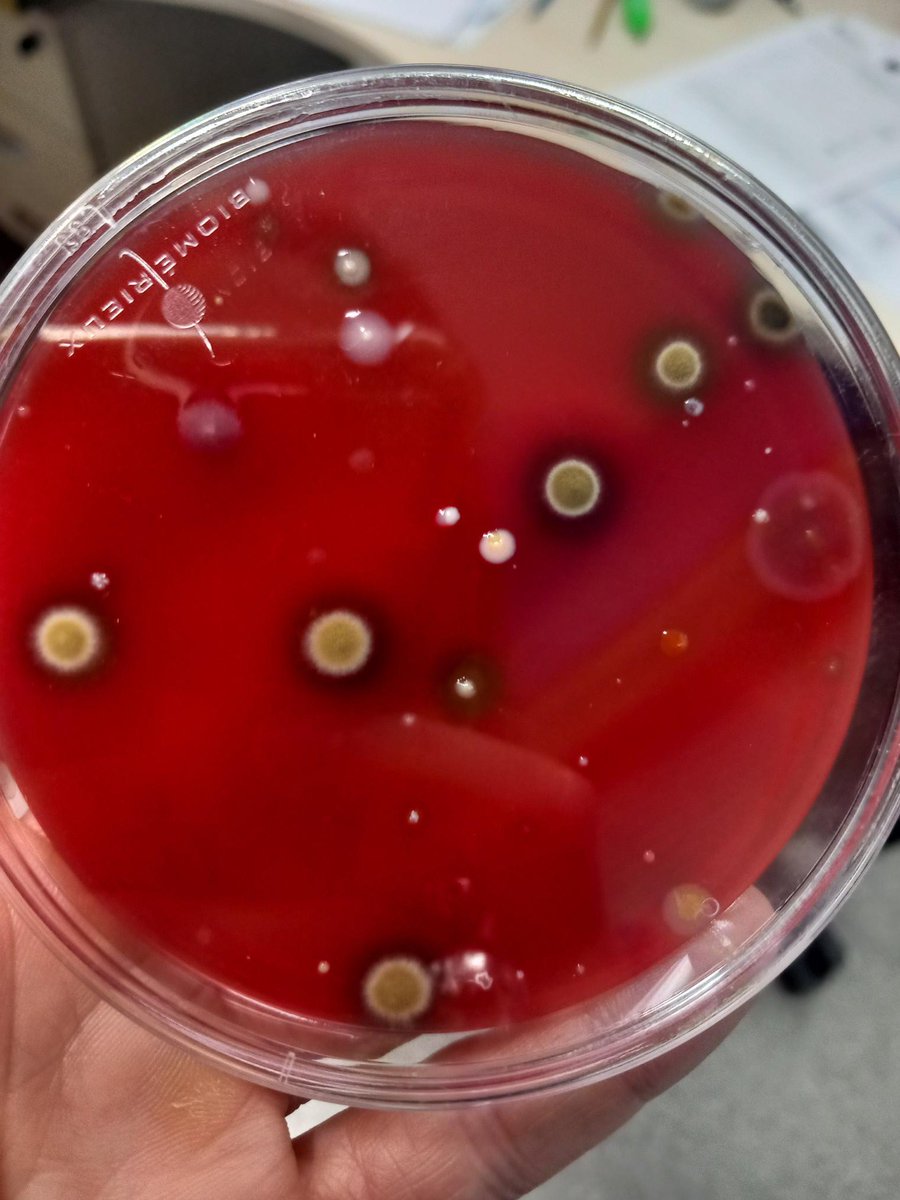
🌿¡¡Aunque el curso de BIOARTE ha terminado, nuestras creaciones siguen vivas¡¡ 🌈✨Gracias Juan Zamora por inspirarnos en estas obras poéticas que continúan evolucionando 🤩#FormacionCyL #InnovaCyL #BIOARTE <a href="/CFIE_Segovia/">CFIE de Segovia</a> <a href="/CSFPJCYL/">CSFP</a>

@Asesoría Plástica_Música_EF_CFIESg
@acfiesg53830
ID: 1856272775679217664
12-11-2024 09:48:24
10 Tweet
3 Takipçi
17 Takip Edilen

🌿✨ ¡Descubre el fascinante mundo del #BIOARTE con el artista Juan Zamora! Únete al curso en el CFIE de Segovia y explora la intersección entre Arte, Educación y Biología. ¡No te lo pierdas! 🎨🔬 Educación JCyL #formacionCyL #innovaCyL



Ayer terminó el curso de COLOR en el MuseoEstebanVicente. ¡Los colores, el blanco y el negro, nos transportaron a un mundo lleno de inspiración, asombro e impresión!🎨🌈


¡Estás a tiempo! 🌱🎨 No pierdas la oportunidad de explorar el fascinante mundo del #Bioarte. Inscríbete en el curso del CFIE de Segovia y descubre cómo la ciencia y el arte se fusionan para crear algo único #EducaciónCreativa #InnovaciónEnElAula





¡📢 ¡Atención a todos los docentes! 📢 Ya está abierta la inscripción para el curso "EL DEPORTE DE ORIENTACIÓN EN EL ÁREA DE EF: APLICACIONES MÓVILES Y NUEVAS TECNOLOGÍAS" en el CFIE de Segovia 📱✨¡No te pierdas esta oportunidad de innovar en tus clases!🚀💡



🎨Con Alas de Papel (ER) 🙌Acto emotivo con palabras de Diego del Pozo 💫Con Fuencisla Francés, nuestra inspiracion 💐Guía de Gael Zamora 🤗Organismos colaboradores 🫂Representación de centros y alumnado CSFP Educación JCyL CEIP San Gil CEE Nuestra Señora de la Esperanza CEIP VILLALPANDO CEIP La Pradera


🚀 ¿Te apetece "LIARTE con proyectos creativos en clave digital"? 🎨 No te pierdas el curso on-line con ROSA LIARTE. 💡¡Inspírate, aprende y crea! Rosa Liarte Alcaine #RosaLiarte #Creatividad


🔊 ¡Ayer arrancó con gran éxito el curso de Rosa Liarte Alcaine en el @CFIESegovia ! Seguimos los próximos días con más sesiones llenas de creatividad y con muuuuucha inspiración 📷 📷📷Educación JCyL 👏


🎨💡¡Creatividad en estado puro! En la 2ª sesión del curso con Rosa Liarte Alcaine del CFIE de Segovia ¡Acabamos siendo noticia! Gracias Rosa por inspirarnos y por hacernos protagonistas de tu historia 👌 #InnovaciónEducativaCyL #CFIESegovia #FormaciónCyL canva.com/design/DAG0qIw…

💟📢 ¡Hoy nos despedimos del curso con Rosa Liarte Alcaine en el CFIE de Segovia liándonos a lo grande! 🎬 Stop Motion,🎙️Radio, 🎨 Canva… ¡¡Creatividad desatada y aprendizaje del bueno!! 👏👏🥳 Educación JCyL #formacionCyL #innovaCyL


📡🎨Abierto plazo de inscripción para el curso "AULA Y MUSEO: EXPOSICIONES Y ARTISTAS COMO EJES DE APRENDIZAJE"🎨 📌Presencial en CFIE de Segovia 📅 11, 13 y 18 de noviembre ✏️ Inscripciones hasta el 6 de noviembre 🔎 Más info: cfiesegovia.centros.educa.jcyl.es/sitio/